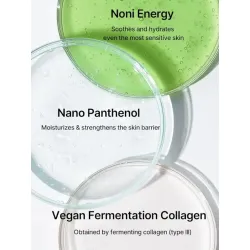

Souffle Color Pot 13 Berry...
• Le produit multi-usage ultime, conçu pour apporter une touche de...

- Efficacité prouvée: La Noni Ampoule Calming Radiance de Celimax est formulée avec de l'extrait de noni, un ingrédient naturel reconnu pour ses propriétés apaisantes et éclaircissantes pour la peau.
- Format pratique: Ce produit est proposé en flacon de 10ml, idéal pour l'emporter partout avec vous et l'utiliser en toute simplicité, que ce soit à la maison ou en déplacement.
- Texture légère: Sa texture légère et non grasse pénètre rapidement dans la peau, la laissant douce, hydratée et lumineuse sans effet collant.
- Résultats visibles: En l'appliquant régulièrement, vous constaterez une diminution des rougeurs et une amélioration de l'éclat de votre peau, pour un teint plus uniforme et lumineux.
Découvrez la Noni Ampoule Calming Radiance de la marque Celimax, un sérum puissant pour apaiser et illuminer la peau. Cette ampoule de 10ml est formulée avec des extraits de Noni, connu pour ses propriétés apaisantes et régénérantes, pour offrir à votre peau un teint éclatant et uniforme.
Mode d'emploi : Appliquez quelques gouttes sur une peau propre et sèche, en tapotant doucement pour une meilleure absorption. Utilisez matin et soir pour des résultats optimaux.
Précaution d'usage : Évitez le contact avec les yeux. En cas d'irritation, cessez l'utilisation et consultez un professionnel de la santé.
Ingrédients : Water, Morinda Citrifolia Fruit Extract, Glycerin, Niacinamide, 1,2-Hexanediol, etc. (Cette liste d'ingrédients représente toutes les options ou variantes de ce produit. Les ingrédients réels dans une option de produit donnée peuvent différer de cette liste. Les ingrédients sont susceptibles de changer à la discrétion du fabricant. Pour la liste d'ingrédients la plus complète et la plus à jour, veuillez vous référer à l'emballage du produit.)
• Le produit multi-usage ultime, conçu pour apporter une touche de...
- Formule douce à base de feuille de madécassoside et d'acide salicylique BHA pour nettoyer en...
- Dissout les points noirs tenaces : Adoucit et dissout les points...
- Formulé à base d'aloe vera, connu pour ses propriétés apaisantes et hydratantes